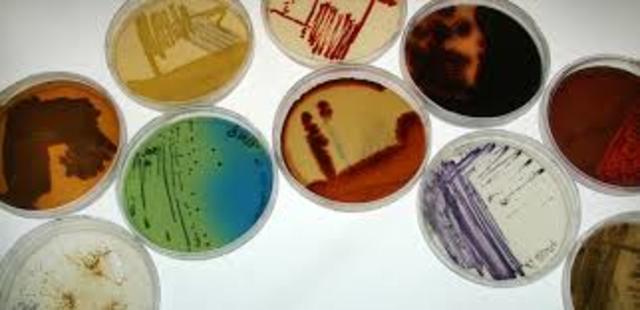
Tratado de Budapest

-
El Convenio de París se aplica a la propiedad industrial en su acepción más amplia, con inclusión de las patentes, las marcas de
productos y servicios, los dibujos y modelos industriales, los modelos de utilidad (una especie de “pequeña patente” establecida
en la legislación de algunos países), las marcas de servicio, los nombres comerciales (la denominación que se emplea para la actividad industrial o comercial), las indicaciones geográficas y la represión de la competencia desleal. -
Fue gracias al impulso del escritor francés Victor Hugo, y su Association littéraire et artistique internationale, que se adoptó el Convenio de Berna para la Protección de las Obras Literarias y Artísticas. Su objetivo es dar a los creadores, en el plano internacional, el derecho a controlar el uso de sus obras creativas y a recibir un pago por ese uso.
-
En el Arreglo se precisan los casos y el modo en que podrá, solicitarse y ejecutarse el embargo. En relación con la venta, la exposición o la oferta a la venta de productos, quedan prohibidas las indicaciones que tengan carácter de publicidad susceptible de inducir al público a error sobre la procedencia del producto en cuestión. Corresponderá a los tribunales de los Estados Contratantes determinar las denominaciones que, y se sustraiga a las disposiciones del Arreglo.
-
Las dos secretarías encargadas de administrar los Convenios de París y Berna se fusionaron conformando la entidad precursora de la OMPI: las Oficinas Internacionales Reunidas para la Protección de la Propiedad Intelectual, mejor conocidas por sus siglas en francés, BIRPI. Esta organización, compuesta por siete funcionarios, tenía su sede en Berna (Suiza).
-
El Arreglo de La Haya permite solicitar el registro de un dibujo o modelo industrial presentando una única solicitud en la Oficina Internacional de la OMPI, es decir que los titulares de dibujos o modelos industriales pueden protegerlos en varios países o regiones. El Arreglo de La Haya también simplifica la gestión de los registros de dibujos o modelos, pues posibilita inscribir modificaciones subsiguientes y renovar el registra internacional realizando un único trámite
-
El Arreglo de Niza establece una clasificación de productos y servicios para el registro de las marcas de fábrica o de comercio y las marcas de servicio (la Clasificación de Niza). En los documentos y publicaciones oficiales correspondientes al registro de la marca las oficinas de marcas de los Estados Contratantes deben indicar los números que señalan las clases de la Clasificación en las cuales se incluyan los productos y servicios que sean objeto del registro.
-
El Arreglo de Lisboa contempla la protección de las denominaciones de origen, o sea, la “denominación geográfica de un país, de una región, o de una localidad que sirva para designar un producto originario del mismo y cuya calidad o características se deben exclusiva o esencialmente al medio geográfico, comprendidos los factores naturales y los factores humanos”.
-
El Convenio de la OMPI, el instrumento constitutivo de la Organización Mundial de la Propiedad Intelectual (OMPI), fue firmado en Estocolmo, entró en vigor en 1970 y fue enmendado en 1979. La OMPI es una organización intergubernamental que en 1974 pasó a ser uno de los organismos especializados del sistema de organizaciones de las Naciones Unidas.
-
Establece una clasificación de los dibujos y modelos industriales. En los títulos oficiales referidos al depósito o al registro de
dibujos o modelos industriales las oficinas competentes de los Estados Contratantes deberán indicar los números correspondientes a las clases y subclases de la Clasificación a las cuales pertenezcan los productos en que se plasmen los dibujos o modelos y tendrán que expresar asimismo la misma indicación en las publicaciones. -
Este tratado permite buscar protección por patente para una invención en muchos países al mismo tiempo mediante la presentación de la solicitud “internacional” de patente. Pueden
presentar dicha solicitud los nacionales o residentes de los Estados Contratantes del PCT. Por lo general, el trámite de presentación se
cumple ante la oficina nacional de patentes del Estado Contratante de nacionalidad o de domicilio del solicitante o, ante la Oficina Internacional de la OMPI, en Ginebra. -
Al entrar en vigor el Convenio que establece la Organización Mundial de la Propiedad Intelectual , las BIRPI se convierten en la OMPI, una nueva organización intergubernamental con sede en Ginebra (Suiza), en la que la iniciativa la llevan sus Estados miembros.
-
El Arreglo de Estrasburgo establece la Clasificación Internacional de Patentes (CIP), que divide la tecnología en ocho secciones que contienen aproximadamente 70.000 subdivisiones. Cada subdivisión está representada por un símbolo formado por números arábigos y letras del alfabeto latino. Este Arreglo creó una Unión y ésta se dotó de una Asamblea que forman los Estados miembros de la Unión. Entre las funciones más importantes figura la aprobación del presupuesto bienal por programas de la Unión.
-
El Acuerdo de Viena establece una clasificación (la Clasificación de Viena) para las marcas que consisten en elementos figurativos o que contienen dichos elementos. En los documentos y publicaciones oficiales relativos a los registros y renovaciones de marcas, las oficinas competentes de los Estados Contratantes deben indicar los números que señalen las categorías, divisiones y secciones de la Clasificación a las cuales correspondan los elementos figurativos de las marcas en cuestión.
-
La OMPI ingresa en la familia de organizaciones de las Naciones Unidas (NN.UU.) en calidad de organismo especializado. Todos los Estados miembros de las NN.UU. están habilitados, aunque no obligados, a ser miembros de los organismos especializados.
-
La característica principal del Tratado de Budapest radica en que los Estados Contratantes que permitan o exijan el depósito de microorganismos a los fines del procedimiento en materia de patentes deberán reconocer, a ese efecto, el depósito de un microorganismo efectuado en una “autoridad internacional de depósito” con independencia de que dicha autoridad se encuentre dentro o fuera del territorio de dicho Estado.
-
El Sistema internacional de patentes en virtud del PCT comienza a funcionar. Gracias a una fuerte expansión, en la actualidad el Sistema del PCT ha pasado a ser el más importante sistema internacional de presentación de solicitudes de derechos de P.I.
-
El objetivo del Tratado sobre el Derecho de Marcas (TLT) es armonizar y agilizar los procedimientos nacionales y regionales de registro de marcas. Esto se logra mediante la simplificación y la unificación de determinados aspectos de esos procedimientos, de forma que la presentación de las solicitudes de registro de marcas y la administración de los registros en varias jurisdicciones resulten tareas menos complicadas y más previsibles.
-
Se crea en la OMPI el Centro de Arbitraje y Mediación para ofrecer servicios extrajudiciales de solución de controversias comerciales internacionales entre partes privadas.
-
Se crea la Academia de la OMPI para impartir cursos generales y especializados en materia de propiedad intelectual. Los cursos de la Academia siguen un enfoque interdisciplinario y están destinados a una amplia gama de profesionales de la P.I.
-
El Tratado sobre el Derecho de Patentes (PLT) tiene por objeto armonizar y agilizar los procedimientos de forma relacionados con las solicitudes de patentes y las patentes nacionales y regionales para facilitar la labor a los usuarios. Con la importante salvedad de los requisitos relativos a la fecha de presentación, el PLT establece una lista máxima de los requisitos que podrán solicitar las oficinas de las Partes Contratantes.
-
El objetivo del Tratado de Singapur es crear un marco internacional moderno y dinámico para la armonización de los trámites administrativos de registro de marcas. Sobre la base del Tratado sobre el Derecho de Marcas de 1994 (el TLT de 1994), el nuevo Tratado de Singapur posee un alcance más amplio y tiene en cuenta la evolución más reciente en el ámbito de las tecnologías de la comunicación.
-
La OMPI adoptó oficialmente su Agenda para el Desarrollo con el propósito de asegurarse la integración de la dimensión de desarrollo en todas las actividades de la Organización.
A list shows items. A timeline shows sequence.
Use Timetoast to make dates, milestones, and turning points easier to understand in a clear visual format. Timetoast is a timeline maker for work, school, research, and stories.